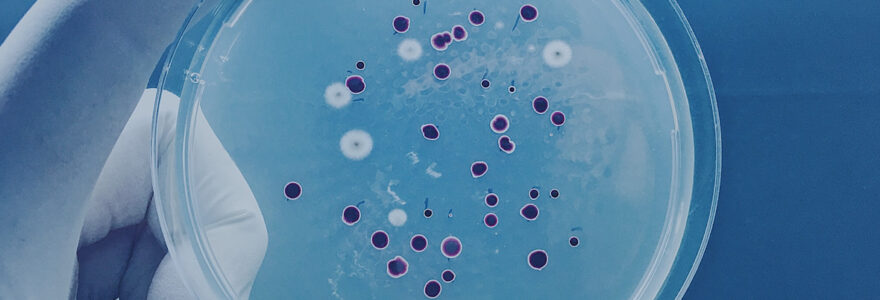

臨床遺伝子
Genetic Engineering

未来の医療の可能性を広げる、
病のメカニズム・治療法を確立する遺伝子研究。
遺伝子情報(DNA,ゲノム)を解析することで、病の原因となる遺伝子を特定することや個々人の遺伝子型に合った治療薬の提供が可能となります。
病に苦しむ患者や支える家族、医療者に新たな光をもたらします。
Genetic Engineering
遺伝子情報(DNA,ゲノム)を解析することで、病の原因となる遺伝子を特定することや個々人の遺伝子型に合った治療薬の提供が可能となります。
病に苦しむ患者や支える家族、医療者に新たな光をもたらします。